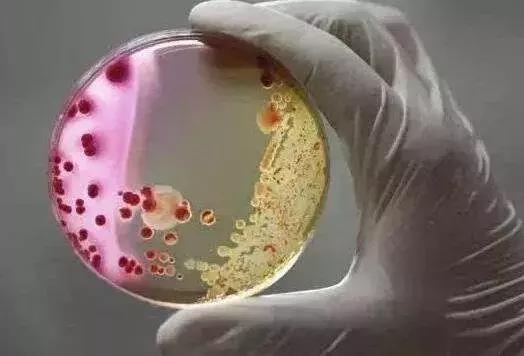
食肉菌感染截肢,食肉菌感染有多可怕

美国研究人员发现致命性食肉菌逃脱人体免疫攻击而“大口吃肉”的把戏,并提出两种潜在治疗方法。

食肉菌是指链球菌等能造成肌肉组织损坏的菌类。感染食肉菌严重时会引发坏死性筋膜炎,身体某处会感到剧痛,随后结缔组织和肌肉组织迅速坏死,死亡率高达30%,存活者也往往要通过手术切除坏死组织甚至截肢。
10日发表在美国《细胞》杂志上的研究显示,导致坏死性筋膜炎的食肉菌化脓性链球菌“绑架”了神经元,利用人体受伤或感染后神经元与免疫系统的正常交流机制存活。
研究称,身体受伤后,神经系统会发出两种信号,一种告诉大脑并产生痛觉;另一个抑制免疫系统,从而避免过度免疫反应对健康组织造成附带伤害。
美国哈佛大学医学院微生物学和免疫生物学助理教授伊萨克·邱领导的研究团队通过小鼠模型发现,食肉菌利用了这种机制,通过释放细菌毒素“链球菌溶血素S”增加宿主疼痛感,并造成免疫沉默。
研究人员让小鼠感染了不表达这种细菌毒素的食肉菌,小鼠则不会表现出疼痛症状,也不会出现坏死性筋膜炎;若使小鼠感染可以表达这种毒素的食肉菌,则会全面发病,而给予让这种毒素失活的中和抗体,疼痛症状会有所缓解。
研究发现,“链球菌溶血素S”接触神经元后,会向大脑发送疼痛信号,导致神经递质“降钙素基因相关肽”的释放,这种神经递质可抑制中性粒细胞,从而抑制免疫反应。
当研究人员向感染小鼠注射和喂食“降钙素基因相关肽”阻断剂,让免疫细胞不听神经元的指挥,食肉菌感染得到了抑制。
此外,研究人员给小鼠注射美容行业用来去除皱纹的神经阻断剂肉毒神经毒素A一周后让小鼠感染食肉菌。与对照组小鼠相比,小的伤口不会导致食肉菌感染。如感染细菌后再注射肉毒神经毒素A,小鼠的感染会得到控制。
“肉毒神经毒素A”已获美国食品和药物管理局批准,“降钙素基因相关肽”阻断剂也即将获药管局批准用于治疗偏头痛,为快速推动坏死性筋膜炎新疗法进入临床提供可能。